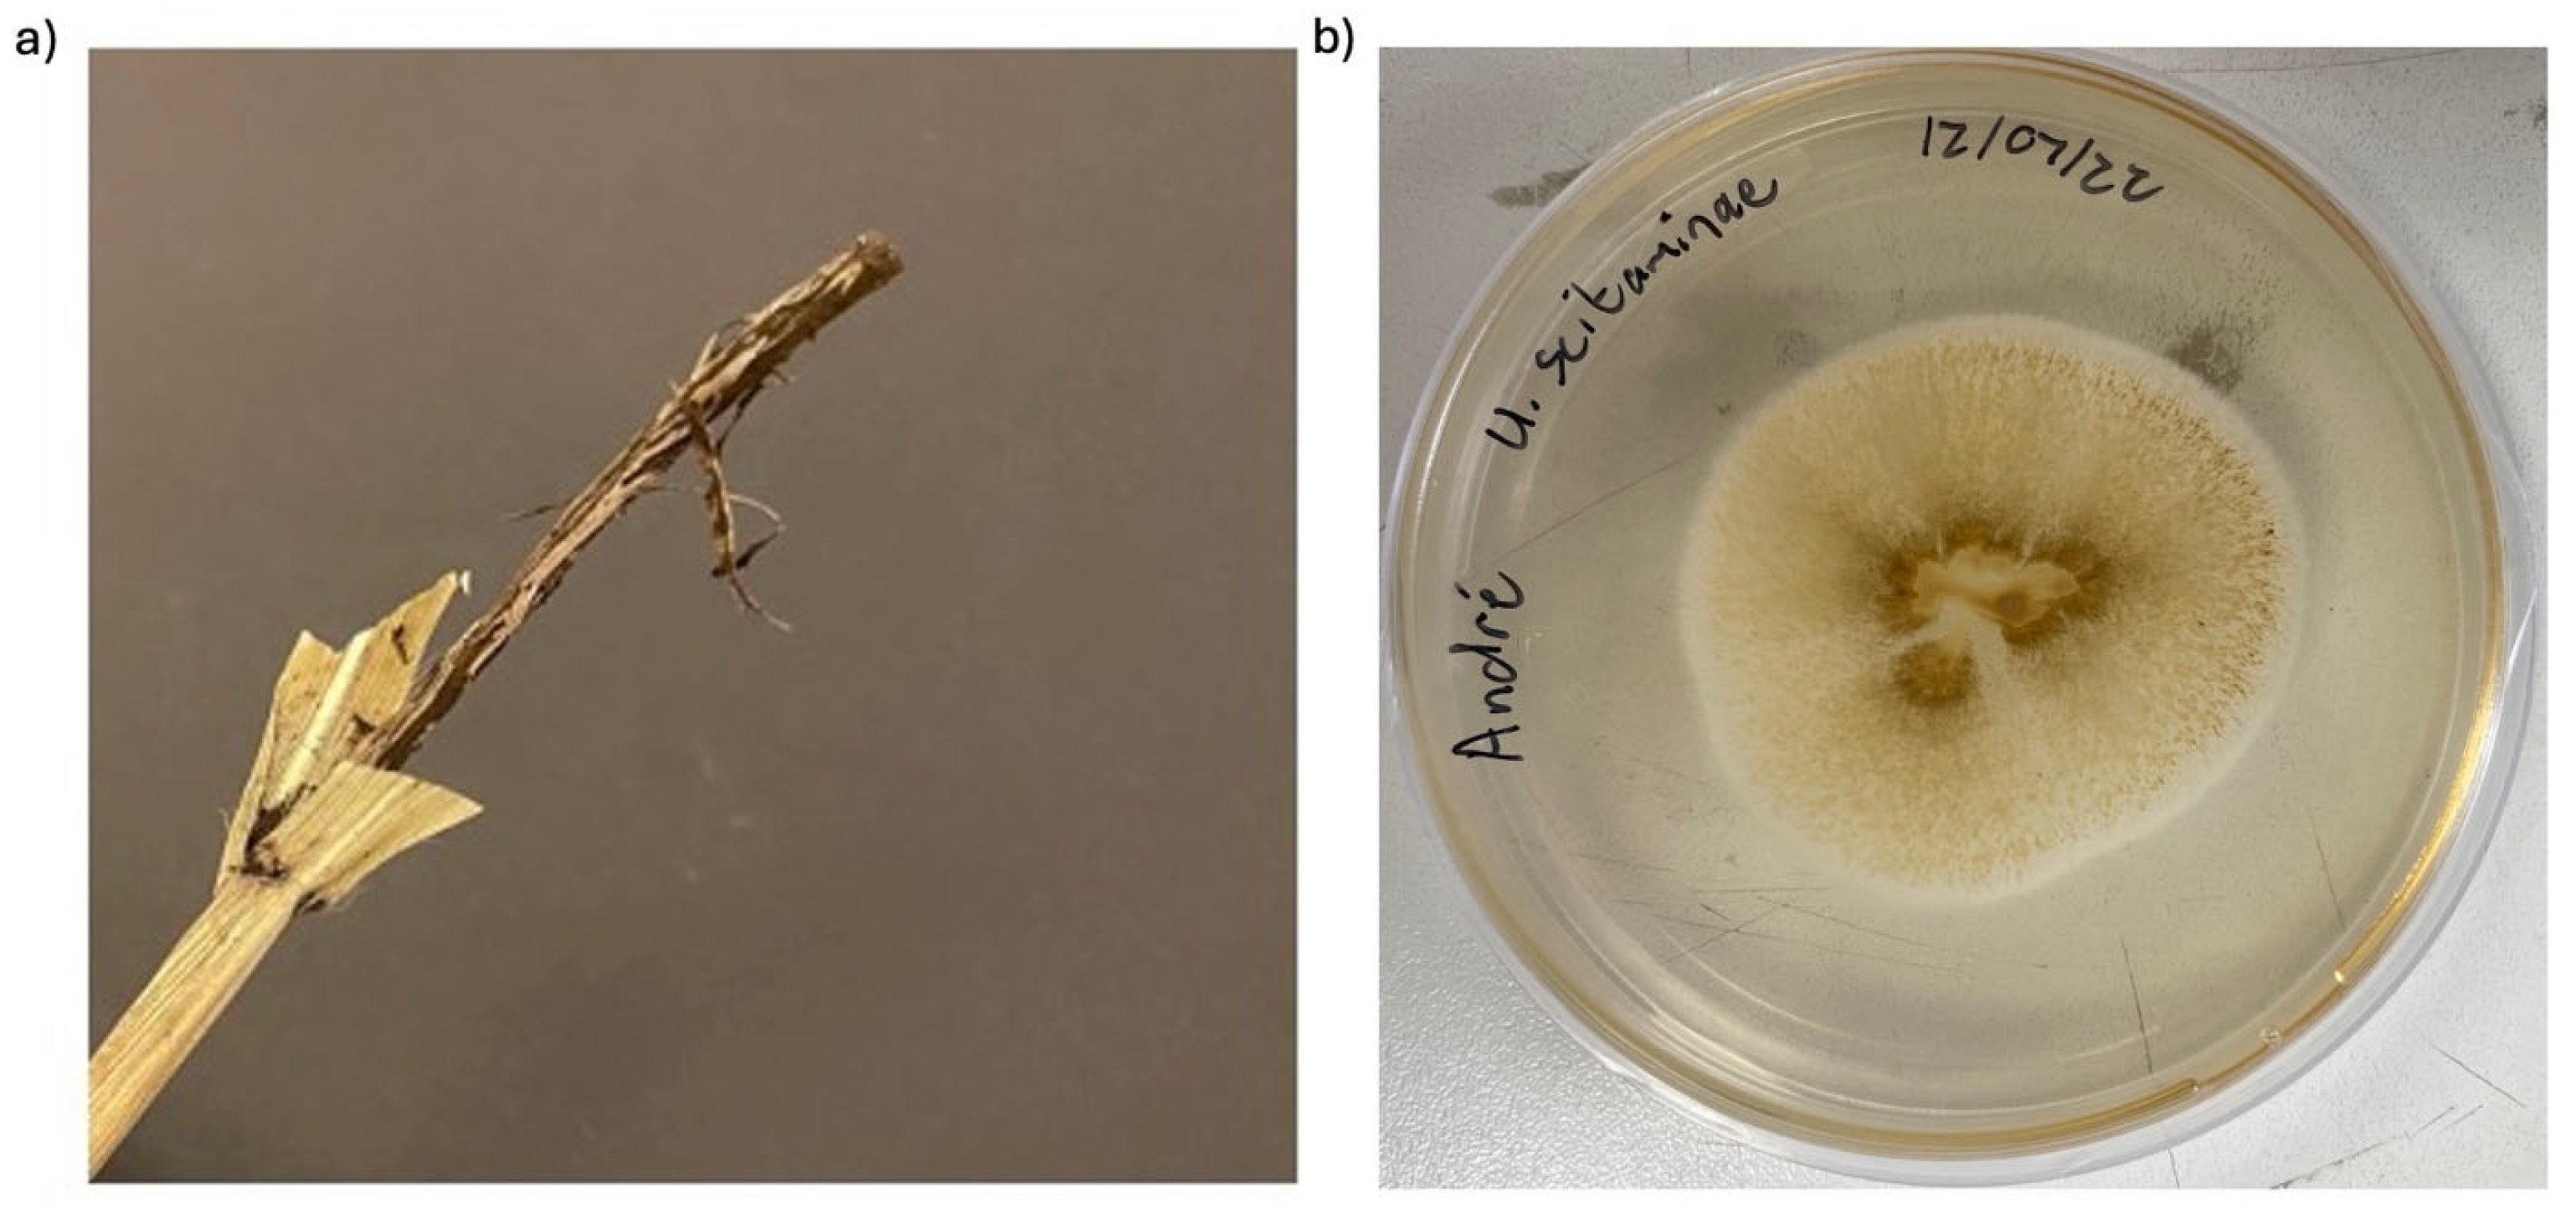
Fermentation 11 00384 g002

Bioprospecting for a Wild Strain of Sporisorium scitamineum for the Valorization of Sugarcane Molasses into Mannosylerythritol Lipids and Cellobiose Lipids
Abstract
1. Introduction
2. Materials and Methods
2.1. Microorganisms
2.2. Chemicals
2.3. Isolation and Genetic Analysis of Wild-Type S. scitamineum
2.3.1. Isolation of S. scitamineum
2.3.2. DNA Extraction, PCR Amplification, and Sequencing
2.3.3. Phylogenetic Analysis
2.4. Culture Conditions
2.4.1. Stock Cultures
2.4.2. Seed Cultures
2.4.3. Co-Production of MELs and CBLs
2.5. Isolation and Purification of MELs and CBLs
2.6. Analytical Methods
2.6.1. Microscope Imaging
2.6.2. UV-Spectrometry
2.6.3. High-Performance Liquid Chromatography
2.7. Calculations
2.8. Statistical Analysis
3. Results
3.1. Isolation and Identification of Wild-Type S. scitamineum
3.2. The Co-Production of MELs and CBLs from Pure Hydrophilic Carbon Sources by Wild-Type S. scitamineum
4. Conclusions
Author Contributions
Funding
Institutional Review Board Statement
Informed Consent Statement
Data Availability Statement
Conflicts of Interest
References
- Formann, S.; Hahn, A.; Janke, L.; Stinner, W.; Sträuber, H.; Logroño, W.; Nikolausz, M. Beyond Sugar and Ethanol Production: Value Generation Opportunities Through Sugarcane Residues. Front. Energy Res. 2020, 8, 267. [Google Scholar] [CrossRef]
- Dinesh Babu, K.S.; Janakiraman, V.; Palaniswamy, H.; Kasirajan, L.; Gomathi, R.; Ramkumar, T.R. A short review on sugarcane: Its domestication, molecular manipulations and future perspectives. Genet. Resour. Crop Evol. 2022, 69, 2623. [Google Scholar] [CrossRef] [PubMed]
- Hawaz, E.; Tafesse, M.; Tesfaye, A.; Kiros, S.; Beyene, D.; Kebede, G.; Boekhout, T.; Groenwald, M.; Theelen, B.; Degefe, A.; et al. Optimization of bioethanol production from sugarcane molasses by the response surface methodology using Meyerozyma caribbica isolate MJTm3. Ann. Microbiol. 2023, 73, 2. [Google Scholar] [CrossRef]
- Luo, R.; Zhang, Y.; Wang, F.; Liu, K.; Huang, G.; Zheng, N.; Wang, J. Effects of Sugar Cane Molasses Addition on the Fermentation Quality, Microbial Community, and Tastes of Alfalfa Silage. Animals 2021, 11, 355. [Google Scholar] [CrossRef]
- Bento, H.B.S.; Carvalho, A.K.F.; Reis, C.E.R.; De Castro, H.F. Single cell oil production and modification for fuel and food applications: Assessing the potential of sugarcane molasses as culture medium for filamentous fungus. Ind. Crops Prod. 2020, 145, 112141. [Google Scholar] [CrossRef]
- Morita, T.; Ishibashi, Y.; Hirose, N.; Wada, K.; Takahashi, M.; Fukuoka, T.; Imura, T.; Sakai, H.; Abe, M.; Kitamoto, D. Production and Characterization of a Glycolipid Biosurfactant, Mannosylerythritol Lipid B, from Sugarcane Juice by Ustilago scitaminea NBRC 32730. Biosci. Biotechnol. Biochem. 2011, 75, 1371–1376. [Google Scholar] [CrossRef]
- Teixeira-Silva, N.S.; Schaker, P.D.C.; Rody, H.V.S.; Maia, T.; Garner, C.M.; Gassmann, W.; Monteiro-Vitorello, C.B. Leaping into the Unknown World of Sporisorium scitamineum Candidate Effectors. J. Fungi 2020, 6, 339. [Google Scholar] [CrossRef]
- Bhuiyan, S.A.; Magarey, R.C.; McNeil, M.D.; Aitken, K.S. Sugarcane Smut, Caused by Sporisorium scitamineum, a Major Disease of Sugarcane: A Contemporary Review. Phytopathology 2021, 111, 1905–1917. [Google Scholar] [CrossRef]
- Oraby, A.; Werner, N.; Sungur, Z.; Zibek, S. Factors Affecting the Synthesis of Cellobiose Lipids by Sporisorium scitamineum. Front. Bioeng. Biotechnol. 2020, 8, 555647. [Google Scholar] [CrossRef]
- Morita, T.; Ishibashi, Y.; Fukuoka, T.; Imura, T.; Sakai, H.; Abe, M.; Kitamoto, D. Production of glycolipid biosurfactants, mannosylerythritol lipids, by a smut fungus, Ustilago scitaminea NBRC 32730. Biosci. Biotechnol. Biochem. 2009, 73, 788–792. [Google Scholar] [CrossRef]
- Kitamoto, D.; Fukuoka, T.; Saika, A.; Morita, T. Glycolipid Biosurfactants, Mannosylerythritol Lipids: Distinctive Interfacial Properties and Applications in Cosmetic and Personal Care Products. J. Oleo Sci. 2021, 71, ess21358. [Google Scholar] [CrossRef] [PubMed]
- Coelho, A.L.S.; Feuser, P.E.; Carciofi, B.A.M.; de Andrade, C.J.; de Oliveira, D. Mannosylerythritol lipids: Antimicrobial and biomedical properties. Appl. Microbiol. Biotechnol. 2020, 104, 2297–2318. [Google Scholar] [CrossRef]
- Kulakovskaya, E.; Baskunov, B.; Zvonarev, A. The Antibiotic and Membrane-damaging Activities of Cellobiose Lipids and Sophorose Lipids. J. Oleo Sci. 2014, 63, 701–707. [Google Scholar] [CrossRef]
- Imura, T.; Kawamura, D.; Ishibashi, Y.; Morita, T.; Sato, S.; Fukuoka, T.; Kikkawa, Y.; Kitamoto, D. Low molecular weight gelators based on biosurfactants, cellobiose lipids by cryptococcus humicola. J. Oleo Sci. 2012, 61, 659–664. [Google Scholar] [CrossRef]
- Imura, T.; Yamamoto, S.; Yamashita, C.; Taira, T.; Minamikawa, H.; Morita, T.; Kitamoto, D. Aqueous Gel Formation from Sodium Salts of Cellobiose Lipids. J. Oleo Sci. 2014, 63, 1005–1010. [Google Scholar] [CrossRef] [PubMed]
- Moldes, A.B.; Rodríguez-López, L.; Rincón-Fontán, M.; López-Prieto, A.; Vecino, X.; Cruz, J.M. Synthetic and Bio-Derived Surfactants Versus Microbial Biosurfactants in the Cosmetic Industry: An Overview. Int. J. Mol. Sci. 2021, 22, 2371. [Google Scholar] [CrossRef] [PubMed]
- Jimoh, A.A.; Lin, J. Biosurfactant: A new frontier for greener technology and environmental sustainability. Ecotoxicol. Environ. Saf. 2019, 184, 109607. [Google Scholar] [CrossRef]
- Shaban, S.M.; Kang, J.; Kim, D.H. Surfactants: Recent advances and their applications. Compos. Commun. 2020, 22, 100537. [Google Scholar] [CrossRef]
- Jahan, R.; Bodratti, A.M.; Tsianou, M.; Alexandridis, P. Biosurfactants, natural alternatives to synthetic surfactants: Physicochemical properties and applications. Adv. Colloid Interface Sci. 2020, 275, 102061. [Google Scholar] [CrossRef]
- Yu, C.; Qi, J.; Han, H.; Wang, P.; Liu, C. Progress in pathogenesis research of Ustilago maydis, and the metabolites involved along with their biosynthesis. Mol. Plant Pathol. 2023, 24, 495. [Google Scholar] [CrossRef]
- Seliger, H. PCR protocols—A guide to methods and applications. Trends Biotechnol. 1990, 8, 335. [Google Scholar] [CrossRef]
- McTaggart, A.R.; Shivas, R.G.; Geering, A.D.W.; Callaghan, B.; Vánky, K.; Scharaschkin, T. Soral synapomorphies are significant for the systematics of the Ustilago-Sporisorium-Macalpinomyces complex (Ustilaginaceae). Persoonia 2012, 29, 63–77. [Google Scholar] [CrossRef]
- Edgar, R.C. MUSCLE: Multiple sequence alignment with high accuracy and high throughput. Nucleic Acids Res. 2004, 32, 1792–1797. [Google Scholar] [CrossRef]
- Ronquist, F.; Teslenko, M.; Van Der Mark, P.; Ayres, D.L.; Darling, A.; Höhna, S.; Larget, B.; Liu, L.; Suchard, M.A.; Huelsenbeck, J.P. MrBayes 3.2: Efficient Bayesian Phylogenetic Inference and Model Choice Across a Large Model Space. Syst. Biol. 2012, 61, 539–542. [Google Scholar] [CrossRef]
- Stamatakis, A. RAxML version 8: A tool for phylogenetic analysis and post-analysis of large phylogenies. Bioinformatics 2014, 30, 1312–1313. [Google Scholar] [CrossRef] [PubMed]
- Morita, T.; Konishi, M.; Fukuoka, T.; Imura, T.; Kitamoto, D. Production of glycolipid biosurfactants, mannosylerythritol lipids, by Pseudozyma siamensis CBS 9960 and their interfacial properties. J. Biosci. Bioeng. 2008, 105, 493–502. [Google Scholar] [CrossRef] [PubMed]
- Morita, T.; Ishibashi, Y.; Fukuoka, T.; Imura, T.; Sakai, H.; Abe, M.; Kitamoto, D. Production of Glycolipid Biosurfactants, Mannosylerythritol Lipids, Using Sucrose by Fungal and Yeast Strains, and Their Interfacial Properties. Biosci. Biotechnol. Biochem. 2009, 73, 2352–2355. [Google Scholar] [CrossRef]
- Arnstein, H.R.V.; Dawson, R.M.C.; Elliott, D.C.; Elliott, W.H.; Jones, K.M. Data for Biochemical Research, 3rd ed.; Clarendon Press: Oxford, UK, 1988; Volume 234, p. 506. [Google Scholar]
- Valkenburg, A.D.; Teke, G.M.; Pott, R.W.M.; van Rensburg, E. The fed-batch production of mannosylerythritol lipids by Ustilago maydis DSM 4500 from hydrophilic carbon sources. Bioprocess. Biosyst. Eng. 2024, 47, 2043–2054. [Google Scholar] [CrossRef]
- Oraby, A.; Rupp, S.; Zibek, S. Techno-Economic Analysis as a Driver for Optimisation of Cellobiose Lipid Fermentation and Purification. Front. Bioeng. Biotechnol. 2022, 10, 913351. [Google Scholar] [CrossRef]
- Morita, T.; Ishibashi, Y.; Fukuoka, T.; Imura, T.; Sakai, H.; Abe, M.; Kitamoto, D. Production of Glycolipid Biosurfactants, Cellobiose Lipids, by Cryptococcus humicola JCM 1461 and Their Interfacial Properties. Biosci. Biotechnol. Biochem. 2011, 75, 1597–1599. [Google Scholar] [CrossRef]
- Zhou, B.; Hao, Q.; Liang, Y.; Kong, E. Protein palmitoylation in cancer: Molecular functions and therapeutic potential. Mol. Oncol 2023, 17, 3–26. [Google Scholar] [CrossRef] [PubMed]
- Martín Ortega, A.M.; Segura Campos, M.R. Macronutrients and micronutrients in cancer prevention and treatment. Oncol. Funct. Nutr. Phytochem. Med. Plants 2021, 99–124. [Google Scholar] [CrossRef]
- Wada, K.; Koike, H.; Fujii, T.; Morita, T. Targeted transcriptomic study of the implication of central metabolic pathways in mannosylerythritol lipids biosynthesis in Pseudozyma antarctica T-34. PLoS ONE 2020, 15, e0227295. [Google Scholar] [CrossRef]
- Beck, A.; Werner, N.; Zibek, S. Mannosylerythritol Lipids: Biosynthesis, Genetics, and Production Strategies. In Biobased Surfactants; Elsevier: Amsterdam, The Netherlands, 2019; pp. 121–167. [Google Scholar]
- Hewald, S.; Josephs, K.; Bölker, M. Genetic analysis of biosurfactant production in Ustilago maydis. Appl. Environ. Microbiol 2005, 71, 3033–3040. [Google Scholar] [CrossRef]
- Tester, R.F.; Karkalas, J.; Qi, X. Starch—Composition, fine structure and architecture. J. Cereal Sci. 2004, 39, 151–165. [Google Scholar] [CrossRef]
- Snetselaar, K.; Mims, C. Infection of maize stigmas by Ustilago maydis: Light and electron microscopy. Phytopathology 1993, 83, 843. [Google Scholar] [CrossRef]
- Sipaúba-Tavares, L.H.; Tedesque, M.G.; Colla, L.C.; Millan, R.N.; Scardoeli-Truzzi, B. Effect of untreated and pretreated sugarcane molasses on growth performance of Haematococcus pluvialis microalgae in inorganic fertilizer and macrophyte extract culture media. Braz. J. Biol. 2022, 82, e263282. [Google Scholar] [CrossRef]

| Carbon Source | CBLs | MELs | ||||||||
|---|---|---|---|---|---|---|---|---|---|---|
| Titre (g/L) | Yield per Biomass Formed (g/g) | Yield per Carbon Consumed (g/g) | Yield per Urea Consumed (g/g) | Production Rate (g/L·d) | Titre (g/L) | Yield per Biomass Formed (g/g) | Yield per Carbon Consumed (g/g) | Yield per Urea Consumed (g/g) | Production Rate (g/L·d) | |
| 50 g/L sucrose | 2.727 ± 0.680 | 0.701 ± 0.785 | 0.075 ± 0.019 | 4.544 ± 1.133 | 0.085 | 0.236 ± 0.046 | 0.061 ± 0.053 | 0.007 ± 0.001 | 0.394 ± 0.077 | 0.006 |
| 50 g/L glucose | 0 ± 0 | 0 ± 0 | 0 ± 0 | 0 ± 0 | 0 | 0 ± 0 | 0 ± 0 | 0 ± 0 | 0 ± 0 | 0 |
| 50 g/L fructose | 0.711 ± 0.615 | 0.208 ± 1.091 | 0.064 ± 0.055 | 1.186 ± 1.025 | 0.077 | 0.022 ± 0.033 | 0.007 ± 0.058 | 0.002 ± 0.003 | 0.037 ± 0.054 | 0.004 |
| Carbon Source | CBLs | MELs | ||||||
|---|---|---|---|---|---|---|---|---|
| Titre (g/L) | Yield per Carbon Consumed (g/g) | Yield per Urea Consumed (g/g) | Production Rate (g/L·d) | Titre (g/L) | Yield per Carbon Consumed (g/g) | Yield per Urea Consumed (g/g) | Production Rate (g/L·d) | |
| 36 g/L sugarcane molasses | 0.750 ± 0.478 | 0.138 ± 0.088 | 1.250 ± 0.797 | 0.107 | 0.246 ± 0.160 | 0.045 ± 0.030 | 0.411 ± 0.267 | 0.035 |
| 72 g/L sugarcane molasses | 1.001 ± 0.106 | 0.088 ± 0.009 | 1.668 ± 0.176 | 0.143 | 0.339 ± 0.044 | 0.030 ± 0.004 | 0.565 ± 0.074 | 0.048 |
| 108 g/L sugarcane molasses | 1.463 ± 0.039 | 0.072 ± 0.002 | 2.439 ± 0.065 | 0.209 | 0.170 ± 0.032 | 0.008 ± 0.002 | 0.283 ± 0.054 | 0.024 |
Disclaimer/Publisher’s Note: The statements, opinions and data contained in all publications are solely those of the individual author(s) and contributor(s) and not of MDPI and/or the editor(s). MDPI and/or the editor(s) disclaim responsibility for any injury to people or property resulting from any ideas, methods, instructions or products referred to in the content. |
© 2025 by the authors. Licensee MDPI, Basel, Switzerland. This article is an open access article distributed under the terms and conditions of the Creative Commons Attribution (CC BY) license (https://creativecommons.org/licenses/by/4.0/).
Share and Cite
Valkenburg, A.D.; van der Merwe, B.; Teke, G.M.; van Rensburg, E.; Pott, R.W.M. Bioprospecting for a Wild Strain of Sporisorium scitamineum for the Valorization of Sugarcane Molasses into Mannosylerythritol Lipids and Cellobiose Lipids. Fermentation 2025, 11, 384. https://doi.org/10.3390/fermentation11070384
Valkenburg AD, van der Merwe B, Teke GM, van Rensburg E, Pott RWM. Bioprospecting for a Wild Strain of Sporisorium scitamineum for the Valorization of Sugarcane Molasses into Mannosylerythritol Lipids and Cellobiose Lipids. Fermentation. 2025; 11(7):384. https://doi.org/10.3390/fermentation11070384
Chicago/Turabian StyleValkenburg, André D., Breyten van der Merwe, George M. Teke, Eugéne van Rensburg, and Robert W. M. Pott. 2025. "Bioprospecting for a Wild Strain of Sporisorium scitamineum for the Valorization of Sugarcane Molasses into Mannosylerythritol Lipids and Cellobiose Lipids" Fermentation 11, no. 7: 384. https://doi.org/10.3390/fermentation11070384
APA StyleValkenburg, A. D., van der Merwe, B., Teke, G. M., van Rensburg, E., & Pott, R. W. M. (2025). Bioprospecting for a Wild Strain of Sporisorium scitamineum for the Valorization of Sugarcane Molasses into Mannosylerythritol Lipids and Cellobiose Lipids. Fermentation, 11(7), 384. https://doi.org/10.3390/fermentation11070384

